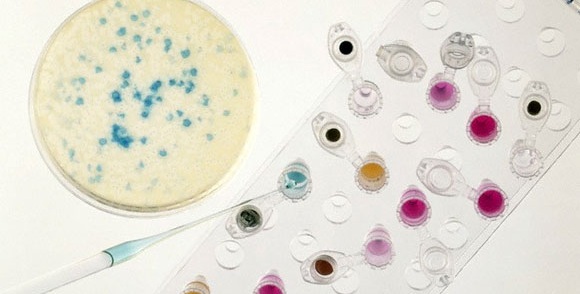

Noticias De "antibióticos"

.Estas son las últimas Noticias De antibióticos. Para más información relevante sobre Noticias De antibióticos, y sobre todo el acontecer nacional e internacional sigue nuestros noticieros mediante nuestra señal en vivo a través de TV EN VIVO GRATIS (Panamericana.pe)
Desde cualquier punto del Perú y/o América Latina, a través de tu PC, tablet o teléfono móvil, podrás ver nuestros noticieros: 24 Horas, Buenos Días Perú y Panorama, así como los programas de entretenimiento y cultura, incluyendo novelas, películas, documentales y las mejores producciones internacionales.
Panamericana TV es la primera cadena televisiva latina en transmitir Televisión en vivo gratis, desde su portal web.
Panamericana Televisión, la televisión que quieres ver.
Desde cualquier punto del Perú y/o América Latina, a través de tu PC, tablet o teléfono móvil, podrás ver nuestros noticieros: 24 Horas, Buenos Días Perú y Panorama, así como los programas de entretenimiento y cultura, incluyendo novelas, películas, documentales y las mejores producciones internacionales.
Panamericana TV es la primera cadena televisiva latina en transmitir Televisión en vivo gratis, desde su portal web.
Panamericana Televisión, la televisión que quieres ver.

Internacionales • Sábado, 12 de octubre del 2024
OMS: “Un mejor uso de las vacunas podría reducir el uso de antibióticos en 2500 millones de dosis al año”

Salud • Lunes, 23 de setiembre del 2024
Alertan sobre impacto de superbacterias: se espera un aumento del 70 % en las muertes hacia 2050

Salud • Lunes, 01 de abril del 2024
Alerta en China: se disparan casos de enfermedad resistente a antibióticos

Locales • Lunes, 30 de enero del 2023
Chosica: Serpiente venenosa muerde a perro y su dueña pide ayuda para conseguir antídoto

Locales • Jueves, 13 de febrero del 2020
Niños aislados con bacterias multirresistentes: “están colonizados pero no enfermos”

Salud • Viernes, 22 de noviembre del 2019
Resistencia a los antibióticos podría ocasionar la muerte de 10 millones de personas

Salud • Martes, 12 de diciembre del 2017
Antibióticos: 4 razones por las que su mal uso es más peligroso que cualquier bacteria

Internacionales • Viernes, 27 de mayo del 2016
EEUU: hallan bacteria que resiste antibióticos

Salud • Sábado, 03 de mayo del 2014
OMS alerta: enfermedades son cada vez más resistentes a los antibióticos
Salud • Lunes, 25 de noviembre del 2013
Alerta mundial por nueva bacteria mortal resistente a los antibióticos

Salud • Jueves, 14 de marzo del 2013


